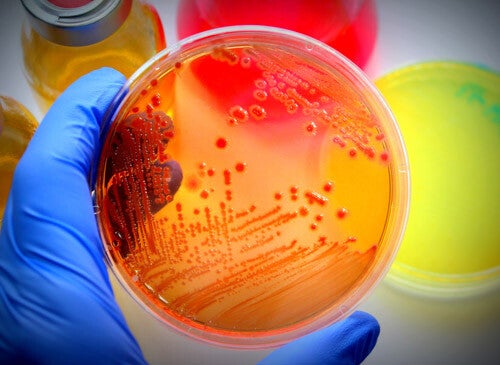

Willkommen bei Hebro Lüftungsreinigung
Hebro Lüftungsreinigung bietet professionelle Reinigung von Lüftungsanlagen in Bochum und Umgebung, sowie bundesweit. Wir sorgen für saubere Luft in Ihrem Gebäude oder Unternehmen.
Das Unternehmen Hebro hat sich als ursprünglicher Spezialist für Lüftungsreinigungen zu einem innovativen, modernen Dienstleistungsunternehmen im Bereich der Reinigung und Pflege von Küchenabluft- und Lüftungsanlagen entwickelt. Wir freuen uns über Ihr Interesse und hoffen, Sie von der Qualität unserer Dienstleistungen überzeugen zu können.

Vertrauen Sie auf unsere
Leistung
Bei Hebro steht Ihr Vertrauen an erster Stelle. Wir sind ein spezialisierter Dienstleister und legen großen Wert auf Qualität, Zuverlässigkeit und Kundenzufriedenheit. Unser Ziel ist es, Ihnen innovative Lösungen anzubieten, die Ihren Bedürfnissen gerecht werden und Ihre Erwartungen übertreffen.

Kundenzufriedenheit
Besonders stolz sind wir auf unseren herausragenden Kundenservice – wir möchten, dass unsere Kunden immer zu 100% zufrieden sind.
Dienstleistungen
Häufig gestellte Fragen
“Die Lüftungsreinigung von Hebro hat unsere Luftqualität deutlich verbessert. Wir sind sehr zufrieden mit dem Service und der Professionalität des Teams.”
Adresse
Frenking 11
44894 Bochum
Telefon
+49 176 32451262
Verbinden